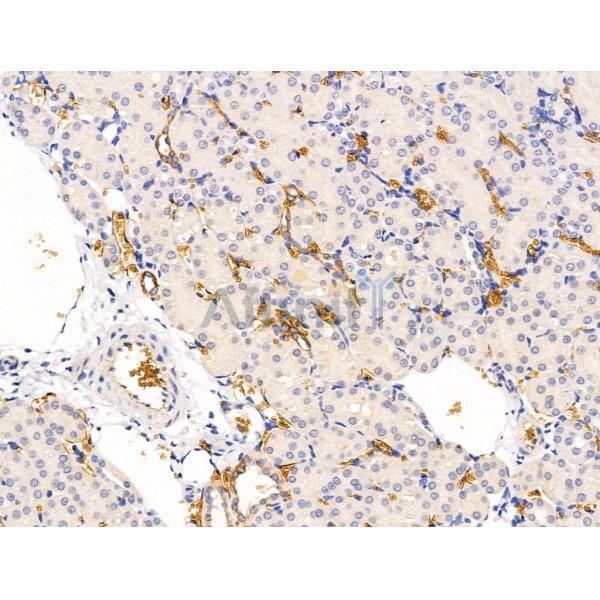
Siglec 7 Antibody - DF13435 at 1/100 staining Mouse kidney tissue by IHC-P.

Siglec 7 Antibody - #DF13435
| Product: | Siglec 7 Antibody |
| Catalog: | DF13435 |
| Description: | Rabbit polyclonal antibody to Siglec 7 |
| Application: | WB IHC |
| Reactivity: | Human, Mouse, Rat |
| Mol.Wt.: | 51kDa; 51kD(Calculated). |
| Uniprot: | Q9Y286 |
| RRID: | AB_2846454 |
Related Downloads
Protocols
Product Info
*The optimal dilutions should be determined by the end user. For optimal experimental results, antibody reuse is not recommended.
*Tips:
WB: For western blot detection of denatured protein samples. IHC: For immunohistochemical detection of paraffin sections (IHC-p) or frozen sections (IHC-f) of tissue samples. IF/ICC: For immunofluorescence detection of cell samples. ELISA(peptide): For ELISA detection of antigenic peptide.
Cite Format: Affinity Biosciences Cat# DF13435, RRID:AB_2846454.
Fold/Unfold
Adhesion inhibitory receptor molecule 1; Adhesion inhibitory receptor molecule 1, siglec 7; AIRM 1; AIRM-1; AIRM1; CD328; CD328 antigen; CDw328; D siglec; D-siglec; HLDA 8; p75; p75/AIRM1; QA79; QA79 membrane protein; Sialic acid binding Ig like lectin 7; Sialic acid binding immunoglobulin like lectin 7; Sialic acid-binding Ig-like lectin 7; SIGL7_HUMAN; Siglec-7; SIGLEC19P; SIGLEC7; SIGLECP2;
Immunogens
A synthesized peptide derived from human Siglec 7, corresponding to a region within C-terminal amino acids.
Predominantly expressed by resting and activated natural killer cells and at lower levels by granulocytes and monocytes. High expression found in placenta, liver, lung, spleen, and peripheral blood leukocytes.
- Q9Y286 SIGL7_HUMAN:
- Protein BLAST With
- NCBI/
- ExPASy/
- Uniprot
MLLLLLLPLLWGRERVEGQKSNRKDYSLTMQSSVTVQEGMCVHVRCSFSYPVDSQTDSDPVHGYWFRAGNDISWKAPVATNNPAWAVQEETRDRFHLLGDPQTKNCTLSIRDARMSDAGRYFFRMEKGNIKWNYKYDQLSVNVTALTHRPNILIPGTLESGCFQNLTCSVPWACEQGTPPMISWMGTSVSPLHPSTTRSSVLTLIPQPQHHGTSLTCQVTLPGAGVTTNRTIQLNVSYPPQNLTVTVFQGEGTASTALGNSSSLSVLEGQSLRLVCAVDSNPPARLSWTWRSLTLYPSQPSNPLVLELQVHLGDEGEFTCRAQNSLGSQHVSLNLSLQQEYTGKMRPVSGVLLGAVGGAGATALVFLSFCVIFIVVRSCRKKSARPAADVGDIGMKDANTIRGSASQGNLTESWADDNPRHHGLAAHSSGEEREIQYAPLSFHKGEPQDLSGQEATNNEYSEIKIPK
Research Backgrounds
Putative adhesion molecule that mediates sialic-acid dependent binding to cells. Preferentially binds to alpha-2,3- and alpha-2,6-linked sialic acid. Also binds disialogangliosides (disialogalactosyl globoside, disialyl lactotetraosylceramide and disialyl GalNAc lactotetraoslylceramide). The sialic acid recognition site may be masked by cis interactions with sialic acids on the same cell surface. In the immune response, may act as an inhibitory receptor upon ligand induced tyrosine phosphorylation by recruiting cytoplasmic phosphatase(s) via their SH2 domain(s) that block signal transduction through dephosphorylation of signaling molecules. Mediates inhibition of natural killer cells cytotoxicity. May play a role in hemopoiesis. Inhibits differentiation of CD34+ cell precursors towards myelomonocytic cell lineage and proliferation of leukemic myeloid cells (in vitro).
Tyrosine phosphorylated.
Membrane>Single-pass type I membrane protein.
Predominantly expressed by resting and activated natural killer cells and at lower levels by granulocytes and monocytes. High expression found in placenta, liver, lung, spleen, and peripheral blood leukocytes.
Contains 1 copy of a cytoplasmic motif that is referred to as the immunoreceptor tyrosine-based inhibitor motif (ITIM). This motif is involved in modulation of cellular responses. The phosphorylated ITIM motif can bind the SH2 domain of several SH2-containing phosphatases.
Belongs to the immunoglobulin superfamily. SIGLEC (sialic acid binding Ig-like lectin) family.
Restrictive clause
Affinity Biosciences tests all products strictly. Citations are provided as a resource for additional applications that have not been validated by Affinity Biosciences. Please choose the appropriate format for each application and consult Materials and Methods sections for additional details about the use of any product in these publications.
For Research Use Only.
Not for use in diagnostic or therapeutic procedures. Not for resale. Not for distribution without written consent. Affinity Biosciences will not be held responsible for patent infringement or other violations that may occur with the use of our products. Affinity Biosciences, Affinity Biosciences Logo and all other trademarks are the property of Affinity Biosciences LTD.